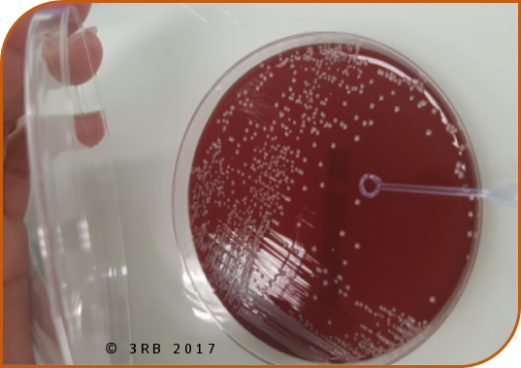

- Accueil
- Ressources 3RB
Secteur du laboratoire : suspension à partir d'une souche en milieu solide
publication le 20/06/2017
Suspension à partir d'une culture en milieu solide
Fichiers téléchargeables :
 fiche de cette analyse globale de la situation professionnelle
fiche de cette analyse globale de la situation professionnelle fiche de l'analyse en détail de la situation professionnelle
fiche de l'analyse en détail de la situation professionnelle
Un technicien de laboratoire d’analyses médicales doit réaliser une suspension à partir d’une culture en milieu solide de Streptococcus pyogenes (streptocoque A).
Analyse de la situation de travail
- Observer et décrire avec précision la situation de travail en utilisant, par exemple, comme méthodes :
- - 5M : Main d'oeuvre, Milieu, Méthode, Matériel, Matière,
- - ITMaMi : Individus, Tâche, Matériel, Milieu ….
- Lister les dangers spécifiques à la situation de travail.
Démarche de prévention du risque biologique
- Repérer dans la chaîne de transmission : agent(s) biologique(s) et réservoir(s), voie(s) d’exposition.
- Identifier la (les) situation(s) exposante(s) au danger.
- Identifier le (les) évènement(s) déclencheur(s).
- Lister le (les) dommage(s) possible(s).
- Proposer des mesures de prévention : intrinsèque, collective, individuelle, instruction / information / formation.
Analyse globale de la situation de travail
Description de la situation de travail (méthode des 5M)
- Main d’œuvre : Technicien de laboratoire d’analyses médicales
- Milieu : laboratoire d’analyses médicales de confinement 2
- Méthode : prélèvement d’une colonie d’une boîte de culture et mise en suspension de la colonie dans un tube de milieu
- Matériel :
- - Anses à usage unique
- - Tube contenant un diluant stérile
- - PSM (Poste de Sécurité Microbiologique)
- - Essuie tout à usage unique
- - Détergent désinfectant
- - Conteneur à DASRI (Déchet d’activités de soins à risque infectieux)
- Matière : gélose au sang avec des colonies de Streptococcus pyogenes
Identification des dangers spécifiques de la situation de travail
- Danger biologique : Streptococcus pyogenes, agent biologique de groupe de danger 2
Démarche de prévention du risque biologique
Repérage dans la chaîne de transmission
- Agents biologiques : Streptococcus pyogenes, agent biologique de groupe 2
- Réservoirs : Boîte de culture
- Voies d’exposition :
- - Voie cutanéo-muqueuse
- - Voie respiratoire
Identification de la (des) situation (s) exposante(s) au danger
- Ouverture de la boîte de culture
- Prélèvement de la colonie
- Mise en suspension dans le diluant par agitation
- Gestion, après usage, du matériel à usage unique (anse, ...)
- Rangement de la zone de travail
Identification du (des) évènement(s) déclencheur(s)
- Contacts cutanés ou contamination d’objets avec des projections créées
lors de l’agitation de l’anse dans le tube de diluant
- Inhalation d’aérosols créés lors de l’ouverture de la boite de culture et de l’homogénéisation de la suspension
Identification du (des) dommage(s)
- Infections cutanées et sous-cutanées
- Angine, scarlatine ...
Proposition de mesures de prévention
- Protection intrinsèque :
- - Utilisation d’anses à usage unique
- - Gestes adaptés pour limiter des aérosols lors de l’ouverture de la boite et de l’homogénéisation des mélanges
- Protection collective :
- - Utilisation d’un PSM si le risque d’occasionner des aérosols n’est pas suffisamment réduit
- - Nettoyage et désinfection régulières du plan de travail
- - Tri et gestion adaptés des déchets
- Protection individuelle :
- - Élimination immédiate, après utilisation, du matériel souillé (anse de prélèvement, tubes ensemencés…) dans le conteneur à DASRI placé à proximité du poste de travail
- - Lavage des mains
- Instruction / Information / Formation :
- - Formation à la démarche de prévention des risques biologiques
- - Mise à disposition et respect de la procédure «Gestion des déchets»
- - Mise à disposition de la procédure «Conduite à tenir en cas d’exposition
à des produits biologiques contaminants»



 fiche de cette analyse globale de la situation professionnelle
fiche de cette analyse globale de la situation professionnelle fiche de l'analyse en détail de la situation professionnelle
fiche de l'analyse en détail de la situation professionnelle